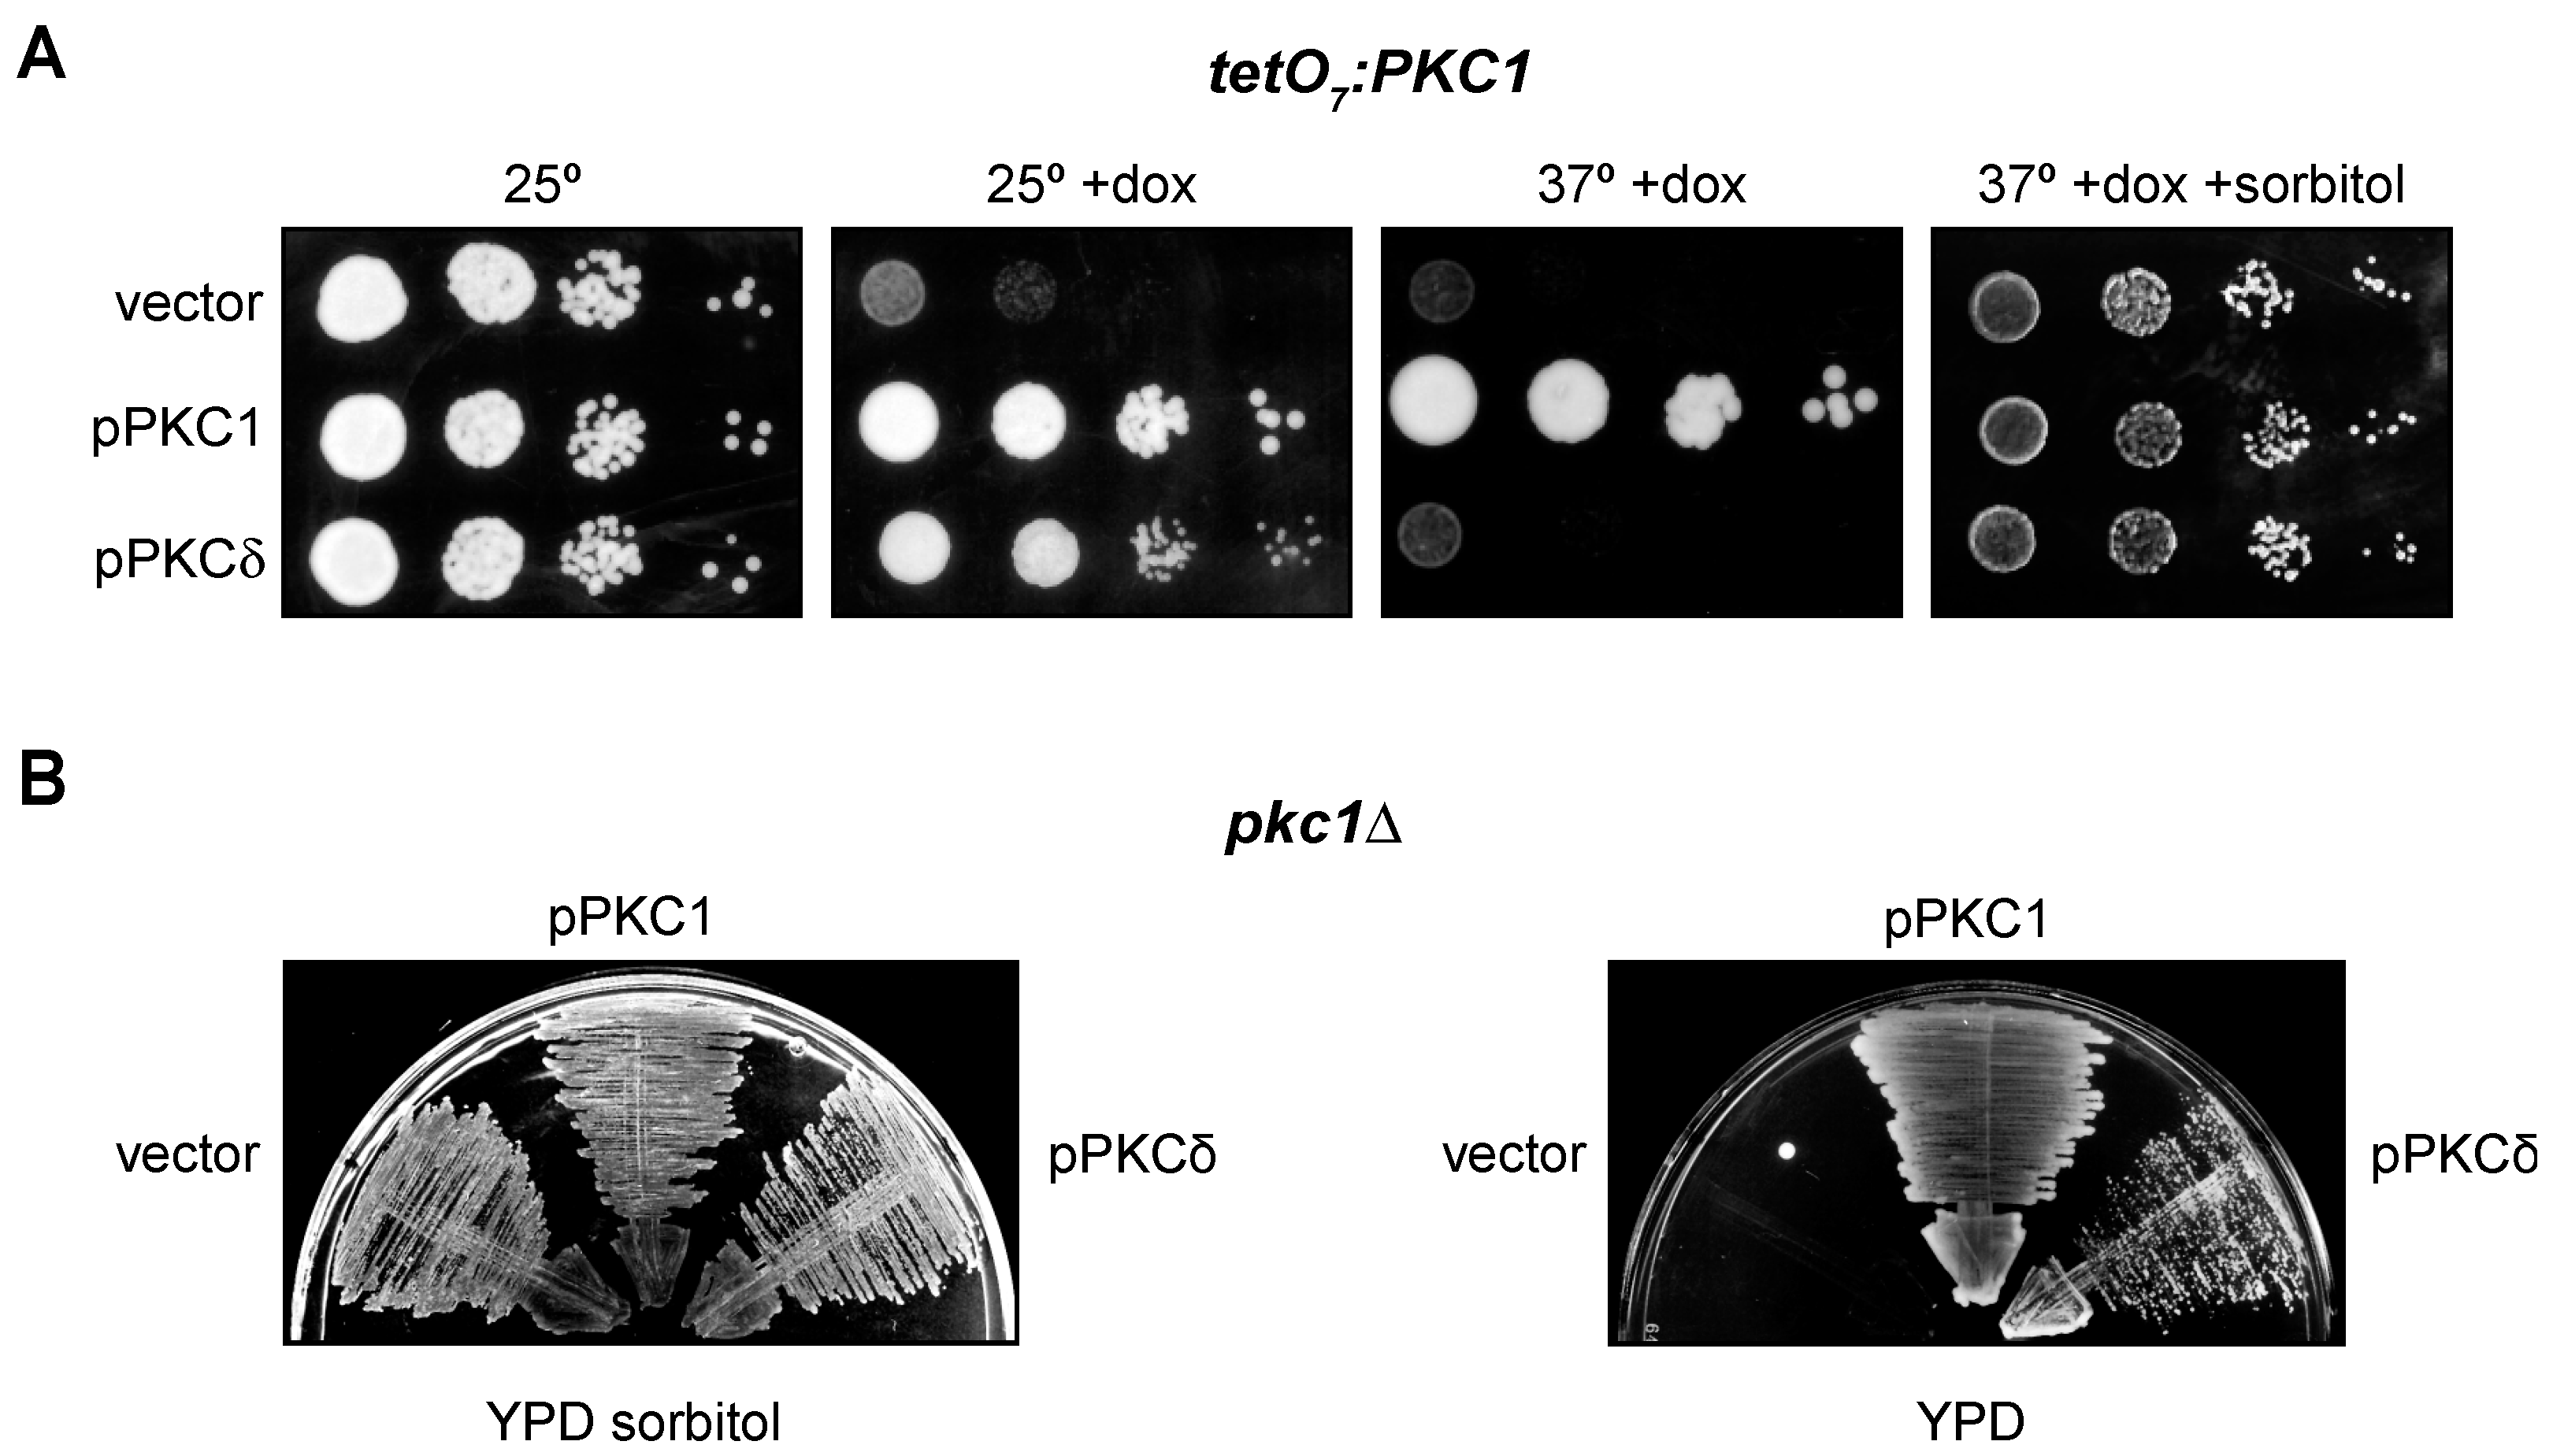

A Multimodel Study of the Role of Novel PKC Isoforms in the DNA Integrity Checkpoint
Abstract
:1. Introduction
2. Results
2.1. PKCδ Plays a Role in the DNA Integrity Checkpoint of mESCs
2.2. PKCδ Partially Suppresses the Growth Defect of pkc1 Yeast Mutant Strains
2.3. The Novel Isoforms PKCδ and PKCθ Are the Only Ones Capable of Performing Pkc1 Functions but with Different Efficiency
2.4. PKCδ and PKCθ Have Different Requirements of Activation Loop Phosphorylation for DNA Integrity Checkpoint Regulation
2.5. Tyr Residues of PKCδ Phosphorylated in Oxidative Stress Are Not Essential for Activating the DNA Integrity Checkpoint
2.6. The Catalytic Fragment of PKCδ, but Not That of PKCθ, Is Sufficient for the Activation of the DNA Integrity Checkpoint in Yeast
2.7. The A-Helix of PKCδ Plays a Role in Activating the DNA Integrity Checkpoint by Providing an Alternative Mechanism to Activation Loop Phosphorylation
3. Discussion
4. Materials and Methods
4.1. Mouse Embryonic Stem Cells Transfection and Growth Conditions
4.2. Yeast Strains and Growth Conditions
4.3. Yeast Plasmids
4.4. Western Blot Analysis
5. Conclusions
Supplementary Materials
Author Contributions
Funding
Institutional Review Board Statement
Data Availability Statement
Conflicts of Interest
References
- Hartwell, L.H.; Weinert, T.A. Checkpoints: Controls That Ensure the Order of Cell Cycle Events. Science 1989, 246, 629–634. [Google Scholar] [CrossRef] [PubMed]
- Amon, A. The Spindle Checkpoint. Curr. Opin. Genet. Dev. 1999, 9, 69–75. [Google Scholar] [CrossRef] [PubMed]
- Musacchio, A. The Molecular Biology of Spindle Assembly Checkpoint Signaling Dynamics. Curr. Biol. CB 2015, 25, R1002–R1018. [Google Scholar] [CrossRef] [PubMed]
- Sczaniecka, M.M.; Hardwick, K.G. The Spindle Checkpoint: How Do Cells Delay Anaphase Onset? SEB Exp. Biol. Ser. 2008, 59, 243–256. [Google Scholar] [PubMed]
- Kono, K.; Al-Zain, A.; Schroeder, L.; Nakanishi, M.; Ikui, A.E. Plasma Membrane/Cell Wall Perturbation Activates a Novel Cell Cycle Checkpoint during G1 in Saccharomyces Cerevisiae. Proc. Natl. Acad. Sci. USA 2016, 113, 6910–6915. [Google Scholar] [CrossRef]
- Lew, D.J. The Morphogenesis Checkpoint: How Yeast Cells Watch Their Figures. Curr. Opin. Cell Biol. 2003, 15, 648–653. [Google Scholar] [CrossRef]
- Piccirillo, S.; Neog, D.; Spade, D.; Van Horn, J.D.; Tiede-Lewis, L.M.; Dallas, S.L.; Kapros, T.; Honigberg, S.M. Shrinking Daughters: Rlm1-Dependent G1/S Checkpoint Maintains Saccharomyces Cerevisiae Daughter Cell Size and Viability. Genetics 2017, 206, 1923–1938. [Google Scholar] [CrossRef]
- Quilis, I.; Gomar-Alba, M.; Igual, J.C. The CWI Pathway: A Versatile Toolbox to Arrest Cell-Cycle Progression. J. Fungi 2021, 7, 1041. [Google Scholar] [CrossRef]
- Suzuki, M.; Igarashi, R.; Sekiya, M.; Utsugi, T.; Morishita, S.; Yukawa, M.; Ohya, Y. Dynactin Is Involved in a Checkpoint to Monitor Cell Wall Synthesis in Saccharomyces Cerevisiae. Nat. Cell Biol. 2004, 6, 861–871. [Google Scholar] [CrossRef]
- Elledge, S.J. Cell Cycle Checkpoints: Preventing an Identity Crisis. Science 1996, 274, 1664–1672. [Google Scholar] [CrossRef]
- Harper, J.W.; Elledge, S.J. The DNA Damage Response: Ten Years After. Mol. Cell 2007, 28, 739–745. [Google Scholar] [CrossRef] [PubMed]
- Lanz, M.C.; Dibitetto, D.; Smolka, M.B. DNA Damage Kinase Signaling: Checkpoint and Repair at 30 Years. EMBO J. 2019, 38, e101801. [Google Scholar] [CrossRef] [PubMed]
- Hoeijmakers, J.H.J. DNA Damage, Aging, and Cancer. N. Engl. J. Med. 2009, 361, 1475–1485. [Google Scholar] [CrossRef] [PubMed]
- Weinert, T.A.; Hartwell, L.H. The RAD9 Gene Controls the Cell Cycle Response to DNA Damage in Saccharomyces Cerevisiae. Science 1988, 241, 317–322. [Google Scholar] [CrossRef]
- Hanahan, D.; Weinberg, R.A. Hallmarks of Cancer: The next Generation. Cell 2011, 144, 646–674. [Google Scholar] [CrossRef]
- Kolodner, R.D.; Putnam, C.D.; Myung, K. Maintenance of Genome Stability in Saccharomyces Cerevisiae. Science 2002, 297, 552–557. [Google Scholar] [CrossRef]
- Matthews, H.K.; Bertoli, C.; de Bruin, R.A.M. Cell Cycle Control in Cancer. Nat. Rev. Mol. Cell Biol. 2022, 23, 74–88. [Google Scholar] [CrossRef]
- Freeley, M.; Kelleher, D.; Long, A. Regulation of Protein Kinase C Function by Phosphorylation on Conserved and Non-Conserved Sites. Cell. Signal. 2011, 23, 753–762. [Google Scholar] [CrossRef]
- Newton, A.C. Protein Kinase C: Perfectly Balanced. Crit. Rev. Biochem. Mol. Biol. 2018, 53, 208–230. [Google Scholar] [CrossRef]
- Isakov, N. Protein Kinase C (PKC) Isoforms in Cancer, Tumor Promotion and Tumor Suppression. Semin. Cancer Biol. 2018, 48, 36–52. [Google Scholar] [CrossRef]
- Newton, A.C. Protein Kinase C as a Tumor Suppressor. Semin. Cancer Biol. 2018, 48, 18–26. [Google Scholar] [CrossRef] [PubMed]
- Arencibia, J.M.; Pastor-Flores, D.; Bauer, A.F.; Schulze, J.O.; Biondi, R.M. AGC Protein Kinases: From Structural Mechanism of Regulation to Allosteric Drug Development for the Treatment of Human Diseases. Biochim. Biophys. Acta 2013, 1834, 1302–1321. [Google Scholar] [CrossRef] [PubMed]
- Reyland, M.E.; Jones, D.N.M. Multifunctional Roles of PKCδ: Opportunities for Targeted Therapy in Human Disease. Pharmacol. Ther. 2016, 165, 1–13. [Google Scholar] [CrossRef] [PubMed]
- Mellor, H.; Parker, P.J. The Extended Protein Kinase C Superfamily. Biochem. J. 1998, 332 Pt 2, 281–292. [Google Scholar] [CrossRef]
- Steinberg, S.F. Structural Basis of Protein Kinase C Isoform Function. Physiol. Rev. 2008, 88, 1341–1378. [Google Scholar] [CrossRef]
- Graybill, C.; Wee, B.; Atwood, S.X.; Prehoda, K.E. Partitioning-Defective Protein 6 (Par-6) Activates Atypical Protein Kinase C (APKC) by Pseudosubstrate Displacement. J. Biol. Chem. 2012, 287, 21003–21011. [Google Scholar] [CrossRef]
- Tobias, I.S.; Newton, A.C. Protein Scaffolds Control Localized Protein Kinase Cζ Activity. J. Biol. Chem. 2016, 291, 13809–13822. [Google Scholar] [CrossRef]
- Tsai, L.-C.L.; Xie, L.; Dore, K.; Xie, L.; Del Rio, J.C.; King, C.C.; Martinez-Ariza, G.; Hulme, C.; Malinow, R.; Bourne, P.E.; et al. Zeta Inhibitory Peptide Disrupts Electrostatic Interactions That Maintain Atypical Protein Kinase C in Its Active Conformation on the Scaffold P62. J. Biol. Chem. 2015, 290, 21845–21856. [Google Scholar] [CrossRef]
- Levin, D.E.; Fields, F.O.; Kunisawa, R.; Bishop, J.M.; Thorner, J. A Candidate Protein Kinase C Gene, PKC1, Is Required for the S. cerevisiae Cell Cycle. Cell 1990, 62, 213–224. [Google Scholar] [CrossRef]
- Levin, D.E.; Bartlett-Heubusch, E. Mutants in the S. Cerevisiae PKC1 Gene Display a Cell Cycle-Specific Osmotic Stability Defect. J. Cell Biol. 1992, 116, 1221–1229. [Google Scholar] [CrossRef]
- Paravicini, G.; Cooper, M.; Friedli, L.; Smith, D.J.; Carpentier, J.L.; Klig, L.S.; Payton, M.A. The Osmotic Integrity of the Yeast Cell Requires a Functional PKC1 Gene Product. Mol. Cell. Biol. 1992, 12, 4896–4905. [Google Scholar] [CrossRef] [PubMed]
- Watanabe, M.; Chen, C.Y.; Levin, D.E. Saccharomyces Cerevisiae PKC1 Encodes a Protein Kinase C (PKC) Homolog with a Substrate Specificity Similar to That of Mammalian PKC. J. Biol. Chem. 1994, 269, 16829–16836. [Google Scholar] [CrossRef] [PubMed]
- Antonsson, B.; Montessuit, S.; Friedli, L.; Payton, M.A.; Paravicini, G. Protein Kinase C in Yeast. Characteristics of the Saccharomyces Cerevisiae PKC1 Gene Product. J. Biol. Chem. 1994, 269, 16821–16828. [Google Scholar] [CrossRef] [PubMed]
- Kamada, Y.; Qadota, H.; Python, C.P.; Anraku, Y.; Ohya, Y.; Levin, D.E. Activation of Yeast Protein Kinase C by Rho1 GTPase. J. Biol. Chem. 1996, 271, 9193–9196. [Google Scholar] [CrossRef]
- Nomura, W.; Ito, Y.; Inoue, Y. Role of Phosphatidylserine in the Activation of Rho1-Related Pkc1 Signaling in Saccharomyces Cerevisiae. Cell. Signal. 2017, 31, 146–153. [Google Scholar] [CrossRef]
- Huang, K.N.; Symington, L.S. Mutation of the Gene Encoding Protein Kinase C 1 Stimulates Mitotic Recombination in Saccharomyces Cerevisiae. Mol. Cell. Biol. 1994, 14, 6039–6045. [Google Scholar] [CrossRef]
- Yang, W.L.; Carman, G.M. Phosphorylation of CTP Synthetase from Saccharomyces Cerevisiae by Protein Kinase C. J. Biol. Chem. 1995, 270, 14983–14988. [Google Scholar] [CrossRef]
- Yang, W.L.; Bruno, M.E.; Carman, G.M. Regulation of Yeast CTP Synthetase Activity by Protein Kinase C. J. Biol. Chem. 1996, 271, 11113–11119. [Google Scholar] [CrossRef]
- Mascaraque, V.; Hernáez, M.L.; Jiménez-Sánchez, M.; Hansen, R.; Gil, C.; Martín, H.; Cid, V.J.; Molina, M. Phosphoproteomic Analysis of Protein Kinase C Signaling in Saccharomyces Cerevisiae Reveals Slt2 Mitogen-Activated Protein Kinase (MAPK)-Dependent Phosphorylation of Eisosome Core Components. Mol. Cell. Proteom. MCP 2013, 12, 557–574. [Google Scholar] [CrossRef]
- Leduc, A.; He, C.H.; Ramotar, D. Disruption of the Saccharomyces Cerevisiae Cell-Wall Pathway Gene SLG1 Causes Hypersensitivity to the Antitumor Drug Bleomycin. Mol. Genet. Genom. MGG 2003, 269, 78–89. [Google Scholar] [CrossRef]
- Queralt, E.; Igual, J.C. Functional Connection between the Clb5 Cyclin, the Protein Kinase C Pathway and the Swi4 Transcription Factor in Saccharomyces Cerevisiae. Genetics 2005, 171, 1485–1498. [Google Scholar] [CrossRef] [PubMed]
- Zu, T.; Verna, J.; Ballester, R. Mutations in WSC Genes for Putative Stress Receptors Result in Sensitivity to Multiple Stress Conditions and Impairment of Rlm1-Dependent Gene Expression in Saccharomyces Cerevisiae. Mol. Genet. Genom. MGG 2001, 266, 142–155. [Google Scholar] [CrossRef] [PubMed]
- Soriano-Carot, M.; Quilis, I.; Bañó, M.C.; Igual, J.C. Protein Kinase C Controls Activation of the DNA Integrity Checkpoint. Nucleic Acids Res. 2014, 42, 7084–7095. [Google Scholar] [CrossRef]
- Liu, L.; Veis, J.; Reiter, W.; Motari, E.; Costello, C.E.; Samuelson, J.C.; Ammerer, G.; Levin, D.E. Regulation of Pkc1 Hyper-Phosphorylation by Genotoxic Stress. J. Fungi 2021, 7, 874. [Google Scholar] [CrossRef]
- Soriano-Carot, M.; Bañó, M.C.; Igual, J.C. The Yeast Mitogen-Activated Protein Kinase Slt2 Is Involved in the Cellular Response to Genotoxic Stress. Cell Div. 2012, 7, 1. [Google Scholar] [CrossRef]
- Basu, A.; Pal, D. Two Faces of Protein Kinase Cδ: The Contrasting Roles of PKCδ in Cell Survival and Cell Death. Sci. World J. 2010, 10, 2272–2284. [Google Scholar] [CrossRef]
- Yoshida, K.; Wang, H.-G.; Miki, Y.; Kufe, D. Protein Kinase Cdelta Is Responsible for Constitutive and DNA Damage-Induced Phosphorylation of Rad9. EMBO J. 2003, 22, 1431–1441. [Google Scholar] [CrossRef]
- Arango, D.; Parihar, A.; Villamena, F.A.; Wang, L.; Freitas, M.A.; Grotewold, E.; Doseff, A.I. Apigenin Induces DNA Damage through the PKCδ-Dependent Activation of ATM and H2AX Causing down-Regulation of Genes Involved in Cell Cycle Control and DNA Repair. Biochem. Pharmacol. 2012, 84, 1571–1580. [Google Scholar] [CrossRef]
- Bharti, A.; Kraeft, S.K.; Gounder, M.; Pandey, P.; Jin, S.; Yuan, Z.M.; Lees-Miller, S.P.; Weichselbaum, R.; Weaver, D.; Chen, L.B.; et al. Inactivation of DNA-Dependent Protein Kinase by Protein Kinase Cdelta: Implications for Apoptosis. Mol. Cell. Biol. 1998, 18, 6719–6728. [Google Scholar] [CrossRef]
- Li, B.; Wang, X.; Rasheed, N.; Hu, Y.; Boast, S.; Ishii, T.; Nakayama, K.; Nakayama, K.I.; Goff, S.P. Distinct Roles of C-Abl and Atm in Oxidative Stress Response Are Mediated by Protein Kinase C Delta. Genes Dev. 2004, 18, 1824–1837. [Google Scholar] [CrossRef]
- Santiago-Walker, A.E.; Fikaris, A.J.; Kao, G.D.; Brown, E.J.; Kazanietz, M.G.; Meinkoth, J.L. Protein Kinase C Delta Stimulates Apoptosis by Initiating G1 Phase Cell Cycle Progression and S Phase Arrest. J. Biol. Chem. 2005, 280, 32107–32114. [Google Scholar] [CrossRef] [PubMed]
- Speidel, J.T.; Affandi, T.; Jones, D.N.M.; Ferrara, S.E.; Reyland, M.E. Functional Proteomic Analysis Reveals Roles for PKCδ in Regulation of Cell Survival and Cell Death: Implications for Cancer Pathogenesis and Therapy. Adv. Biol. Regul. 2020, 78, 100757. [Google Scholar] [CrossRef] [PubMed]
- Liu, H.; Lu, Z.-G.; Miki, Y.; Yoshida, K. Protein Kinase C Delta Induces Transcription of the TP53 Tumor Suppressor Gene by Controlling Death-Promoting Factor Btf in the Apoptotic Response to DNA Damage. Mol. Cell. Biol. 2007, 27, 8480–8491. [Google Scholar] [CrossRef] [PubMed]
- Nakagawa, M.; Oliva, J.L.; Kothapalli, D.; Fournier, A.; Assoian, R.K.; Kazanietz, M.G. Phorbol Ester-Induced G1 Phase Arrest Selectively Mediated by Protein Kinase Cdelta-Dependent Induction of P21. J. Biol. Chem. 2005, 280, 33926–33934. [Google Scholar] [CrossRef] [PubMed]
- Saha, K.; Adhikary, G.; Kanade, S.R.; Rorke, E.A.; Eckert, R.L. P38δ Regulates P53 to Control P21Cip1 Expression in Human Epidermal Keratinocytes. J. Biol. Chem. 2014, 289, 11443–11453. [Google Scholar] [CrossRef]
- LaGory, E.L.; Sitailo, L.A.; Denning, M.F. The Protein Kinase Cdelta Catalytic Fragment Is Critical for Maintenance of the G2/M DNA Damage Checkpoint. J. Biol. Chem. 2010, 285, 1879–1887. [Google Scholar] [CrossRef]
- Griner, E.M.; Kazanietz, M.G. Protein Kinase C and Other Diacylglycerol Effectors in Cancer. Nat. Rev. Cancer 2007, 7, 281–294. [Google Scholar] [CrossRef]
- Liu, L.; Michowski, W.; Kolodziejczyk, A.; Sicinski, P. The Cell Cycle in Stem Cell Proliferation, Pluripotency and Differentiation. Nat. Cell Biol. 2019, 21, 1060–1067. [Google Scholar] [CrossRef]
- Chen, Z.; Forman, L.W.; Williams, R.M.; Faller, D.V. Protein Kinase C-δ Inactivation Inhibits the Proliferation and Survival of Cancer Stem Cells in Culture and in Vivo. BMC Cancer 2014, 14, 90. [Google Scholar] [CrossRef]
- Levin, D.E. Regulation of Cell Wall Biogenesis in Saccharomyces Cerevisiae: The Cell Wall Integrity Signaling Pathway. Genetics 2011, 189, 1145–1175. [Google Scholar] [CrossRef]
- Stempka, L.; Girod, A.; Müller, H.J.; Rincke, G.; Marks, F.; Gschwendt, M.; Bossemeyer, D. Phosphorylation of Protein Kinase Cdelta (PKCdelta) at Threonine 505 Is Not a Prerequisite for Enzymatic Activity. Expression of Rat PKCdelta and an Alanine 505 Mutant in Bacteria in a Functional Form. J. Biol. Chem. 1997, 272, 6805–6811. [Google Scholar] [CrossRef] [PubMed]
- Stempka, L.; Schnölzer, M.; Radke, S.; Rincke, G.; Marks, F.; Gschwendt, M. Requirements of Protein Kinase Cdelta for Catalytic Function. Role of Glutamic Acid 500 and Autophosphorylation on Serine 643. J. Biol. Chem. 1999, 274, 8886–8892. [Google Scholar] [CrossRef] [PubMed]
- Liu, Y.; Graham, C.; Li, A.; Fisher, R.J.; Shaw, S. Phosphorylation of the Protein Kinase C-Theta Activation Loop and Hydrophobic Motif Regulates Its Kinase Activity, but Only Activation Loop Phosphorylation Is Critical to in Vivo Nuclear-Factor-KappaB Induction. Biochem. J. 2002, 361, 255–265. [Google Scholar] [CrossRef] [PubMed]
- Konishi, H.; Tanaka, M.; Takemura, Y.; Matsuzaki, H.; Ono, Y.; Kikkawa, U.; Nishizuka, Y. Activation of Protein Kinase C by Tyrosine Phosphorylation in Response to H2O2. Proc. Natl. Acad. Sci. USA 1997, 94, 11233–11237. [Google Scholar] [CrossRef] [PubMed]
- Konishi, H.; Yamauchi, E.; Taniguchi, H.; Yamamoto, T.; Matsuzaki, H.; Takemura, Y.; Ohmae, K.; Kikkawa, U.; Nishizuka, Y. Phosphorylation Sites of Protein Kinase C Delta in H2O2-Treated Cells and Its Activation by Tyrosine Kinase in Vitro. Proc. Natl. Acad. Sci. USA 2001, 98, 6587–6592. [Google Scholar] [CrossRef]
- Xu, Z.-B.; Chaudhary, D.; Olland, S.; Wolfrom, S.; Czerwinski, R.; Malakian, K.; Lin, L.; Stahl, M.L.; Joseph-McCarthy, D.; Benander, C.; et al. Catalytic Domain Crystal Structure of Protein Kinase C-Theta (PKCtheta). J. Biol. Chem. 2004, 279, 50401–50409. [Google Scholar] [CrossRef]
- Liu, Y.; Belkina, N.V.; Graham, C.; Shaw, S. Independence of Protein Kinase C-δ Activity from Activation Loop Phosphorylation: Structural Basis and Altered Functions in Cells. J. Biol. Chem. 2006, 281, 12102–12111. [Google Scholar] [CrossRef]
- Duina, A.A.; Miller, M.E.; Keeney, J.B. Budding Yeast for Budding Geneticists: A Primer on the Saccharomyces Cerevisiae Model System. Genetics 2014, 197, 33–48. [Google Scholar] [CrossRef]
- Basu, S.; Greenwood, J.; Jones, A.W.; Nurse, P. Core Control Principles of the Eukaryotic Cell Cycle. Nature 2022, 607, 381–386. [Google Scholar] [CrossRef]
- Emoto, Y.; Manome, Y.; Meinhardt, G.; Kisaki, H.; Kharbanda, S.; Robertson, M.; Ghayur, T.; Wong, W.W.; Kamen, R.; Weichselbaum, R. Proteolytic Activation of Protein Kinase C Delta by an ICE-like Protease in Apoptotic Cells. EMBO J. 1995, 14, 6148–6156. [Google Scholar] [CrossRef]
- Ghayur, T.; Hugunin, M.; Talanian, R.V.; Ratnofsky, S.; Quinlan, C.; Emoto, Y.; Pandey, P.; Datta, R.; Huang, Y.; Kharbanda, S.; et al. Proteolytic Activation of Protein Kinase C Delta by an ICE/CED 3-like Protease Induces Characteristics of Apoptosis. J. Exp. Med. 1996, 184, 2399–2404. [Google Scholar] [CrossRef] [PubMed]
- Basu, A.; Woolard, M.D.; Johnson, C.L. Involvement of Protein Kinase C-Delta in DNA Damage-Induced Apoptosis. Cell Death Differ. 2001, 8, 899–908. [Google Scholar] [CrossRef] [PubMed]
- Datta, R.; Kojima, H.; Yoshida, K.; Kufe, D. Caspase-3-Mediated Cleavage of Protein Kinase C Theta in Induction of Apoptosis. J. Biol. Chem. 1997, 272, 20317–20320. [Google Scholar] [CrossRef] [PubMed]
- Zhao, Y.; Lei, M.; Wang, Z.; Qiao, G.; Yang, T.; Zhang, J. TCR-Induced, PKC-θ-Mediated NF-ΚB Activation Is Regulated by a Caspase-8-Caspase-9-Caspase-3 Cascade. Biochem. Biophys. Res. Commun. 2014, 450, 526–531. [Google Scholar] [CrossRef]
- Villalba, M.; Bushway, P.; Altman, A. Protein Kinase C-Theta Mediates a Selective T Cell Survival Signal via Phosphorylation of BAD. J. Immunol. Baltim. Md 1950 2001, 166, 5955–5963. [Google Scholar] [CrossRef]
- Adwan, T.S.; Ohm, A.M.; Jones, D.N.M.; Humphries, M.J.; Reyland, M.E. Regulated Binding of Importin-α to Protein Kinase Cδ in Response to Apoptotic Signals Facilitates Nuclear Import. J. Biol. Chem. 2011, 286, 35716–35724. [Google Scholar] [CrossRef]
- DeVries, T.A.; Neville, M.C.; Reyland, M.E. Nuclear Import of PKCdelta Is Required for Apoptosis: Identification of a Novel Nuclear Import Sequence. EMBO J. 2002, 21, 6050–6060. [Google Scholar] [CrossRef]
- Humphries, M.J.; Ohm, A.M.; Schaack, J.; Adwan, T.S.; Reyland, M.E. Tyrosine Phosphorylation Regulates Nuclear Translocation of PKCdelta. Oncogene 2008, 27, 3045–3053. [Google Scholar] [CrossRef]
- Sutcliffe, E.L.; Li, J.; Zafar, A.; Hardy, K.; Ghildyal, R.; McCuaig, R.; Norris, N.C.; Lim, P.S.; Milburn, P.J.; Casarotto, M.G.; et al. Chromatinized Protein Kinase C-θ: Can It Escape the Clutches of NF-ΚB? Front. Immunol. 2012, 3, 260. [Google Scholar] [CrossRef]
- Kikkawa, U.; Matsuzaki, H.; Yamamoto, T. Protein Kinase C Delta (PKC Delta): Activation Mechanisms and Functions. J. Biochem. 2002, 132, 831–839. [Google Scholar] [CrossRef]
- Zhao, M.; Xia, L.; Chen, G.-Q. Protein Kinase Cδ in Apoptosis: A Brief Overview. Arch. Immunol. Ther. Exp. 2012, 60, 361–372. [Google Scholar] [CrossRef] [PubMed]
- Baier, G.; Telford, D.; Giampa, L.; Coggeshall, K.M.; Baier-Bitterlich, G.; Isakov, N.; Altman, A. Molecular Cloning and Characterization of PKC Theta, a Novel Member of the Protein Kinase C (PKC) Gene Family Expressed Predominantly in Hematopoietic Cells. J. Biol. Chem. 1993, 268, 4997–5004. [Google Scholar] [CrossRef] [PubMed]
- Osada, S.; Mizuno, K.; Saido, T.C.; Suzuki, K.; Kuroki, T.; Ohno, S. A New Member of the Protein Kinase C Family, NPKC Theta, Predominantly Expressed in Skeletal Muscle. Mol. Cell. Biol. 1992, 12, 3930–3938. [Google Scholar] [CrossRef] [PubMed]
- Hayashi, K.; Altman, A. Protein Kinase C Theta (PKCtheta): A Key Player in T Cell Life and Death. Pharmacol. Res. 2007, 55, 537–544. [Google Scholar] [CrossRef]
- Sasahara, Y.; Rachid, R.; Byrne, M.J.; de la Fuente, M.A.; Abraham, R.T.; Ramesh, N.; Geha, R.S. Mechanism of Recruitment of WASP to the Immunological Synapse and of Its Activation Following TCR Ligation. Mol. Cell 2002, 10, 1269–1281. [Google Scholar] [CrossRef]
- Nicolle, A.; Zhang, Y.; Belguise, K. The Emerging Function of PKCtheta in Cancer. Biomolecules 2021, 11, 221. [Google Scholar] [CrossRef]
- Vitale, I.; Manic, G.; De Maria, R.; Kroemer, G.; Galluzzi, L. DNA Damage in Stem Cells. Mol. Cell 2017, 66, 306–319. [Google Scholar] [CrossRef]
- Alcantara Llaguno, S.; Sun, D.; Pedraza, A.M.; Vera, E.; Wang, Z.; Burns, D.K.; Parada, L.F. Cell-of-Origin Susceptibility to Glioblastoma Formation Declines with Neural Lineage Restriction. Nat. Neurosci. 2019, 22, 545–555. [Google Scholar] [CrossRef]
- Lee, J.H.; Lee, J.E.; Kahng, J.Y.; Kim, S.H.; Park, J.S.; Yoon, S.J.; Um, J.-Y.; Kim, W.K.; Lee, J.-K.; Park, J.; et al. Human Glioblastoma Arises from Subventricular Zone Cells with Low-Level Driver Mutations. Nature 2018, 560, 243–247. [Google Scholar] [CrossRef]
- Geribaldi-Doldán, N.; Hervás-Corpión, I.; Gómez-Oliva, R.; Domínguez-García, S.; Ruiz, F.A.; Iglesias-Lozano, I.; Carrascal, L.; Pardillo-Díaz, R.; Gil-Salú, J.L.; Nunez-Abades, P.; et al. Targeting Protein Kinase C in Glioblastoma Treatment. Biomedicines 2021, 9, 381. [Google Scholar] [CrossRef]
- Hooper, M.; Hardy, K.; Handyside, A.; Hunter, S.; Monk, M. HPRT-Deficient (Lesch-Nyhan) Mouse Embryos Derived from Germline Colonization by Cultured Cells. Nature 1987, 326, 292–295. [Google Scholar] [CrossRef] [PubMed]
- Oldenburg, K.R.; Vo, K.T.; Michaelis, S.; Paddon, C. Recombination-Mediated PCR-Directed Plasmid Construction in Vivo in Yeast. Nucleic Acids Res. 1997, 25, 451–452. [Google Scholar] [CrossRef] [PubMed]

Disclaimer/Publisher’s Note: The statements, opinions and data contained in all publications are solely those of the individual author(s) and contributor(s) and not of MDPI and/or the editor(s). MDPI and/or the editor(s) disclaim responsibility for any injury to people or property resulting from any ideas, methods, instructions or products referred to in the content. |
© 2023 by the authors. Licensee MDPI, Basel, Switzerland. This article is an open access article distributed under the terms and conditions of the Creative Commons Attribution (CC BY) license (https://creativecommons.org/licenses/by/4.0/).
Share and Cite
Saiz-Baggetto, S.; Dolz-Edo, L.; Méndez, E.; García-Bolufer, P.; Marí, M.; Bañó, M.C.; Fariñas, I.; Morante-Redolat, J.M.; Igual, J.C.; Quilis, I. A Multimodel Study of the Role of Novel PKC Isoforms in the DNA Integrity Checkpoint. Int. J. Mol. Sci. 2023, 24, 15796. https://doi.org/10.3390/ijms242115796
Saiz-Baggetto S, Dolz-Edo L, Méndez E, García-Bolufer P, Marí M, Bañó MC, Fariñas I, Morante-Redolat JM, Igual JC, Quilis I. A Multimodel Study of the Role of Novel PKC Isoforms in the DNA Integrity Checkpoint. International Journal of Molecular Sciences. 2023; 24(21):15796. https://doi.org/10.3390/ijms242115796
Chicago/Turabian StyleSaiz-Baggetto, Sara, Laura Dolz-Edo, Ester Méndez, Pau García-Bolufer, Miquel Marí, M. Carmen Bañó, Isabel Fariñas, José Manuel Morante-Redolat, J. Carlos Igual, and Inma Quilis. 2023. "A Multimodel Study of the Role of Novel PKC Isoforms in the DNA Integrity Checkpoint" International Journal of Molecular Sciences 24, no. 21: 15796. https://doi.org/10.3390/ijms242115796
APA StyleSaiz-Baggetto, S., Dolz-Edo, L., Méndez, E., García-Bolufer, P., Marí, M., Bañó, M. C., Fariñas, I., Morante-Redolat, J. M., Igual, J. C., & Quilis, I. (2023). A Multimodel Study of the Role of Novel PKC Isoforms in the DNA Integrity Checkpoint. International Journal of Molecular Sciences, 24(21), 15796. https://doi.org/10.3390/ijms242115796

